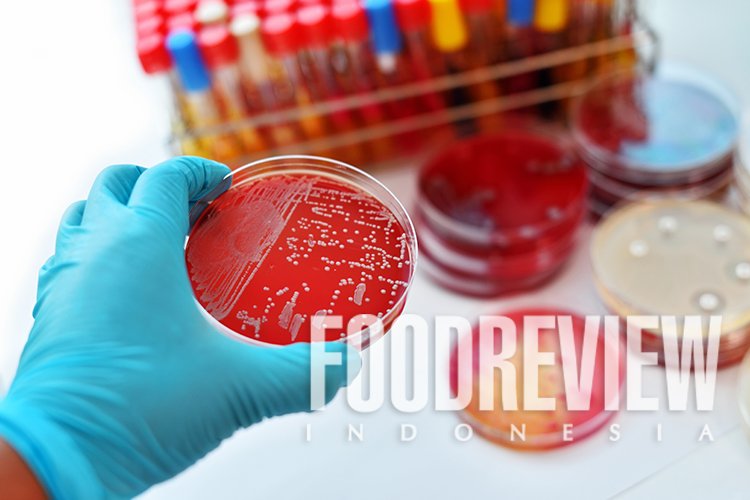

Tantangan dalam analisis kuantitatif lebih kepada perkembangan regulasi yang semakin ketat, baik dari segi jenis senyawa yang lebih bervariasi maupun tuntutan limit deteksi yang semakin rendah konsentrasinya. Sebagai contoh, konsentrasi residu antibiotik dalam produk boga bohari (seafood) di level part per billion (ppb) sebelumnya sudah cukup, namun perkembangannya saat ini menuntut kemampuan laboratorium mendeteksi sampai level part per trillion (ppt).
Lebih lengkapnya silakan baca di Foodreview Indonesia edisi April 2020, Food Analysis: Ask The Right Question. Pembelian & Berlangganan hubungi kami: langganan@foodreview.co.id / (0251) 8372-333 / WA 0811-1190-039.
Lebih lengkapnya silakan baca di Foodreview Indonesia edisi April 2020, Food Analysis: Ask The Right Question. Pembelian & Berlangganan hubungi kami: langganan@foodreview.co.id / (0251) 8372-333 / WA 0811-1190-039.
Newsletter: http://bit.ly/fricommunity
Search FOODREVIEW on TOKOPEDIA

